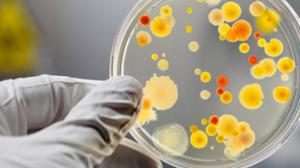
image

Вирус папилломы человека (ВПЧ) — распространенная инфекция, передающаяся половым путем, затрагивающая как женщин, так и мужчин. Мужчины могут не осознавать наличие вируса, однако он может вызывать симптомы и осложнения, включая бородавки и предраковые состояния. В статье рассмотрим основные симптомы ВПЧ у мужчин, методы диагностики и современные подходы к лечению и удалению проявлений вируса. Это знание поможет мужчинам лучше понимать свое здоровье и обращаться за медицинской помощью.
Вирус папилломы человека у мужчин
Мужчина может заразиться вирусом папилломы человека (ВПЧ) различными способами, среди которых выделяют следующие:
- Половой контакт без применения презерватива. Важно отметить, что это касается всех видов контактов – вагинального, анального и орального. Именно таким образом передаются наиболее опасные штаммы вируса.
- Переливание крови от инфицированного человека к здоровому.
- Использование медицинских инструментов, которые были недостаточно обработаны.
- Применение личных вещей инфицированного человека, таких как нижнее белье, полотенца или зубные щетки.
- Также зафиксированы случаи передачи вируса через общую посуду или в местах общественного пользования.
Следует помнить, что вирус не передается воздушно-капельным путем, а только через половые контакты или при непосредственном контакте с кожей.
Эксперты подчеркивают, что вирус папилломы человека у мужчин часто протекает бессимптомно, что затрудняет его раннюю диагностику. Однако в некоторых случаях могут проявляться бородавки или изменения на коже, что требует внимания. Лечение ВПЧ у мужчин включает как местные препараты, так и хирургические методы удаления образований. Важно отметить, что многие типы вируса могут исчезать самостоятельно, но в случае хронической инфекции необходимо регулярное наблюдение. Специалисты рекомендуют вакцинацию как эффективную меру профилактики, особенно для молодежи. Своевременное обращение к врачу и соблюдение рекомендаций помогут минимизировать риски и сохранить здоровье.

Характеристика вируса папилломы человека
Вирус папилломы человека или его называют ВЧП ⏤ тип вирусной инфекции, при которой на коже образуются наросты и папилломы. У мужчин, как и у женщин вероятность заражения вирусом одинаковая.
ВЧП может долгое время находиться в организме в состоянии “сна”. Это плохо, так как любой вирус лучше всего лечить на ранних стадиях заражения.
Папилломы формируются на кожном покрове человека, также на слизистых. Наиболее неприятными местами, где может возникнуть нарост, являются лицо, гортань, половые органы, пах, подмышечная зона.
В этих местах папилломы доставляют либо большой дискомфорт, либо сильные болезненные ощущения.
| Аспект | Описание | Важные моменты |
|---|---|---|
| Симптомы ВПЧ у мужчин | Чаще всего ВПЧ протекает бессимптомно. Основное проявление – остроконечные кондиломы (бородавки) на половых органах, вокруг ануса, во рту или горле. Могут быть плоские кондиломы, папилломы. | Симптомы могут появиться через недели, месяцы или даже годы после заражения. Некоторые типы ВПЧ могут вызывать предраковые изменения, которые не имеют видимых симптомов. |
| Диагностика ВПЧ у мужчин | Визуальный осмотр врачом (урологом, дерматовенерологом). ПЦР-тест для определения типа ВПЧ и его онкогенности. Биопсия подозрительных образований. | Важно обратиться к врачу при появлении любых новообразований. Регулярные осмотры рекомендуются мужчинам, ведущим активную половую жизнь. |
| Лечение ВПЧ у мужчин | Специфического противовирусного лечения ВПЧ не существует. Лечение направлено на удаление кондилом и укрепление иммунитета. | Лечение не гарантирует полного избавления от вируса, но помогает устранить внешние проявления и снизить риск передачи. |
| Удаление кондилом | Хирургическое иссечение: удаление скальпелем. Криодеструкция: замораживание жидким азотом. Лазерное удаление: выпаривание лазером. Электрокоагуляция: прижигание электрическим током. Химическое удаление: применение специальных растворов. | Выбор метода зависит от размера, количества и расположения кондилом. Процедуры проводятся под местной анестезией. Возможны рецидивы. |
| Профилактика ВПЧ у мужчин | Вакцинация: вакцина против ВПЧ (Гардасил, Церварикс) эффективна для профилактики заражения онкогенными типами ВПЧ. Барьерные методы контрацепции: презервативы снижают риск передачи, но не исключают его полностью. Моногамные отношения: снижение числа половых партнеров. | Вакцинация рекомендуется мальчикам и молодым мужчинам до начала половой жизни. Даже после вакцинации важно соблюдать меры предосторожности. |
| Осложнения ВПЧ у мужчин | Рецидивы кондилом. Развитие предраковых состояний и рака (рак полового члена, рак ануса, рак ротоглотки) при заражении онкогенными типами ВПЧ. | Ранняя диагностика и лечение предраковых состояний значительно улучшают прогноз. |
Интересные факты
Вот несколько интересных фактов о вирусе папилломы человека (ВПЧ) у мужчин:
-
Бессимптомное течение: У большинства мужчин инфекция ВПЧ протекает бессимптомно и может исчезать самостоятельно без какого-либо лечения. Однако в некоторых случаях вирус может привести к образованию бородавок или даже к более серьезным заболеваниям, таким как рак полового члена или анального канала.
-
Вакцинация: Существуют вакцины против ВПЧ, которые могут значительно снизить риск заражения вирусом и его последствиями. Вакцинация рекомендуется не только для женщин, но и для мужчин, особенно в подростковом возрасте, чтобы предотвратить развитие рака и других заболеваний, связанных с ВПЧ.
-
Методы удаления: Если у мужчины развиваются бородавки, существует несколько методов их удаления, включая криотерапию (замораживание), лазерное удаление и хирургическое вмешательство. Однако важно помнить, что удаление бородавок не устраняет сам вирус из организма, и он может оставаться в неактивной форме.

Как ВПЧ передаётся мужчинам и женщинам?
Вирусная инфекция характеризуется высокой степенью заразности. Она передаётся от инфицированного человека к здоровому. Около 80% случаев передачи происходит в результате близких контактов.
К основным способам передачи патогенных штаммов относятся:
- Половой — сексуальные отношения, независимо от методов контрацепции и типа секса;
- Контактно-бытовой — поцелуи, взаимодействие через общие предметы и средства личной гигиены;
- Самозаражение — при недостаточном соблюдении гигиенических норм, а также во время эпиляции, бритья или маникюра;
- Родовой — когда мать передаёт инфекцию новорождённому во время родов.
Важно! Вирус сохраняет свою активность в тёплой и влажной среде, поэтому крайне важно соблюдать правила личной гигиены в общественных местах, таких как туалеты, сауны, бани и бассейны.
Как выглядит папиллома у мужчин?
Папилломы на теле мужчин относятся к доброкачественным наростам, по цвету схожим с оттенком кожных покровов. Цвет может варьировать от телесного до коричневатого. Папилломы по внешнему виду напоминают сосочки на тонкой ножке. Мягкая структура нароста и тонкая ножка склонны к травматизации, воспалению.
Папилломы могут быть единичными и множественными. В местах большого скопления представляют целые конгломераты из разных по калибру новообразований.

Почему мужчины заражаются ВПЧ?
Вирус папилломы у мужчин передается через прямой контакт с инфицированным человеком, а также через общие предметы быта и половые отношения.
Наиболее уязвимыми местами для заражения являются общественные пространства: транспорт, магазины, бассейны и тренажерные залы.
Использование презервативов не гарантирует защиту от вируса папилломы во время полового акта. Также существует риск передачи вируса при родах.
В этом случае вирус может передаваться от матери к ребенку в процессе появления на свет.
Вирус начинает проявляться и активироваться, когда иммунная система уже не в состоянии контролировать его.
Презерватив не обеспечивает защиту от заражения ВПЧ.
Существует несколько факторов, способствующих ослаблению иммунной системы и, как следствие, активизации вируса папилломы человека:
- Основная причина — иммунодефицит. Организм теряет способность бороться с инфекцией. У людей, инфицированных ВИЧ, часто наблюдается заражение папилломавирусом из-за ослабленного иммунитета.
- Вредные привычки: злоупотребление алкоголем, курение и употребление наркотиков.
- Неправильное питание. Пища, богатая жирами, солью и сахаром, может содержать много калорий, но не приносит организму пользы. Регулярное употребление фаст-фуда лишает организм необходимых витаминов и минералов.
- Низкая физическая активность и малоподвижный образ жизни.
- Нарушение режима сна и постоянные стрессовые ситуации.
- Беспорядочные половые связи.
Таким образом, около 70% людей на планете сталкивались с вирусом папилломы человека. Из них 13% ведут активную и беспорядочную половую жизнь.
У многих мужчин вирусная инфекция возникает именно по этой причине. Более того, они могут не подозревать о своем носительстве вируса и заражать своих партнеров во время полового акта.
Какие проблемы со здоровьем вызывает ВПЧ у мужчин?
Большинство мужчин с этим вирусом (любого типа) никогда не столкнутся с его проявлениями или проблемами со здоровьем. Однако некоторые типы вируса могут вызывать генитальные бородавки. Другие разновидности способны стать причиной рака пениса, ануса или ротоглотки (задняя сторона горла, включающая основание языка и гланды).
Вирус папилломы у мужчин симптомы
Множество мужчин являются носителями вируса папилломы человека (ВПЧ), но, к сожалению, многие из них даже не догадываются об этом. Некоторые могут прожить всю жизнь, так и не узнав о наличии вируса. Это связано с тем, что первые признаки папилломы или ВПЧ у мужчин могут не проявляться, поскольку крепкий иммунитет способен справляться с инфекцией. Однако при ослаблении иммунной системы могут появиться первые симптомы, которые зависят от типа ВПЧ, атакующего организм.
Симптомы вируса папилломы человека у мужчин могут включать:
-
На коже могут возникать бородавки, которые могут локализоваться в различных местах, как на слизистых оболочках, так и на коже. Они выглядят как небольшие пузырьки размером до одного сантиметра, с разнообразной формой — от овальной до асимметричной. На таких бородавках можно заметить множество мелких выступающих наростов.
-
Появление папиллом на теле у мужчин является явным признаком активности вируса папилломы человека. Эти образования представляют собой небольшие плотные наросты круглой формы, размер которых может варьироваться от нескольких миллиметров до нескольких сантиметров. Цвет таких наростов может быть как коричневым, так и горчичным. Заболевание может быстро распространяться.
-
Кондиломы — это образования, напоминающие бородавки, но с остроконечной формой и растущие на тонкой ножке. Они чаще всего локализуются на слизистых оболочках половых органов. Эти наросты выглядят довольно неприятно и могут вызывать чувство отвращения.
-
Папулез — это сопутствующее заболевание, возникающее в результате атаки вируса. На коже появляются образования розового цвета размером в несколько миллиметров. К сожалению, самостоятельно определить, является ли это опасным, невозможно, и для этого мужчинам необходимо пройти определенные анализы.
-
Болезнь Боуэна — еще одно заболевание, возникающее под воздействием вируса папилломы человека. На половом члене формируются небольшие красные бляшки с четкими границами и круглой формой.
Важно отметить, что все перечисленные заболевания могут прогрессировать и затрагивать новые участки тела. Поэтому симптомы папилломы человека на половом члене у мужчин не следует игнорировать.
Причины
Доминирующая причина инфицирования папилломавирусом – ослабленный иммунитет. Если защитные свойства организма мужчины высокие, даже при контакте с партнершей, инфицированной ВПЧ, патогенный возбудитель может не передаться. При несколько сниженном иммунитете болезнетворный возбудитель способен проникнуть в кровь мужчины, но не проявляться выраженной симптоматикой, не доставлять дискомфорта. В этом случае речь идет о статусе носителя. Поэтому основными факторами, вызывающими ВПЧ, являются все состояния, при которых снижен иммунный ответ организма.
Врожденные и приобретенные иммунодефициты
Иммунодефициты можно разделить на два типа: те, которые возникают в процессе эмбрионального развития, и те, что появляются на протяжении жизни. В первом случае нарушения связаны с негативным воздействием различных факторов на организм матери, включая лекарства, стресс и условия окружающей среды.
Состояния, способствующие снижению иммунитета у мужчин на протяжении жизни:
- Период восстановления после хирургического вмешательства
- Голодание
- Туберкулез
- Работа в условиях высокой токсичности
- Перенесенные ожоги
- Период после значительной кровопотери
- Постоянное воздействие стрессовых факторов
- Наличие хронических воспалительных процессов в организме
- ВИЧ/СПИД
- Глистные инвазии
- Злоупотребление алкоголем
- Сахарный диабет и другие заболевания, связанные с гормональными нарушениями
- Естественный процесс старения
При приобретенном иммунодефиците пациентам рекомендуется улучшить качество питания и использовать средства, способствующие укреплению иммунной системы. В случае значительной потери крови проводят гемотрансфузию для восстановления объема крови. Эти лечебные мероприятия помогают повысить защитные функции организма, что способствует более быстрому устранению ВПЧ.
Постоянная смена сексуальных партнерш
Беспорядочная интимная жизнь – основной путь поражения вирусом папилломы. При этом, сама женщина может не знать о наличии у нее ВПЧ, являясь зараженной или имея статус носителя. Если у мужчины нет постоянной половой партнерши, ему следует пользоваться презервативами. Это позволит избежать инфицирования заболеванием, которое характеризуется высокой онкогенностью.
Незащищенный половой акт
Если ваша партнерша является носителем вируса, то при интимной близости без использования средств контрацепции мужчина может заразиться папилломавирусом. Этот вирус присутствует на слизистой оболочке половых органов и с высокой вероятностью передается на ткани пениса. Из всех методов контрацепции только презервативы обеспечивают защиту от заражения ВПЧ. Другие способы предохраняют от нежелательной беременности, но не могут гарантировать защиту от инфицирования вирусом папилломы.
СПИД, ВИЧ
Тяжелые варианты иммунодефицитных состояний, повышающих риск инфицирования большим количеством патогенных возбудителей – простых и сложных форм. Если у мужчины, страдающего ВИЧ или СПИД, возникает папилломавирус, ему усиливают дозировку препаратов, которые он принимает по поводу основной болезни. Это «поддерживающие» лекарственные средства, повышающие иммунный ответ организма. Такие препараты вводят инфузионным способом – посредством постановки капельниц.
Длительный прием антибиотиков
Длительное применение антибиотиков может негативно сказаться на кишечной микрофлоре и ослабить иммунную систему. Это особенно актуально, если лекарства принимаются без контроля специалиста. В случаях, когда мужчине необходимо назначение антибиотиков по медицинским показаниям, важно одновременно использовать препараты, способствующие укреплению иммунитета. Такие средства могут быть представлены в виде таблеток, суппозиториев или инъекций. Чтобы предотвратить возникновение иммунодефицита, крайне не рекомендуется использовать антибактериальные препараты без предварительной консультации с врачом.
Вирусные инфекции
Циркуляция вирусов в крови снижает иммунитет, создает благоприятное условие для заражения более сложными патогенными микроорганизмами, к числу которых относится ВПЧ. Подобное происходит на фоне отягощенных респираторных инфекций, вируса герпеса, кори или гепатита. Единственное верное решение – одновременно с лечением основной болезни укреплять иммунитет за счет улучшения качества питания, введения витаминов.
Хронические патологии мочеполовой системы
К таким заболеваниям относятся простатит, орхит, орхоэпидидимит, везикулит, пиелонефрит, цистит и уретрит. Эти состояния характеризуются воспалением предстательной железы, яичек с придатками, семенных пузырьков, почек, мочевого пузыря и мочеиспускательного канала. Основные факторы, способствующие развитию указанных заболеваний:
- переохлаждение
- наследственная предрасположенность
- наличие венерических инфекций или интимные отношения с партнёршей, страдающей от венерических заболеваний
- чрезмерное употребление алкоголя
- травмы паховой области, такие как удар или падение на твёрдые поверхности
- отсутствие постоянной половой партнёрши; частые случаи возбуждения без последующей интимной близости
- длительное удерживание мочи
Если мужчина не обращается за медицинской помощью, острые воспаления могут быстро перейти в хроническую форму. Это также может произойти при неправильном лечении. Будучи источником постоянного воспаления, указанные заболевания снижают иммунные силы организма, что мешает ему адекватно реагировать на атаки патогенной микрофлоры. Чтобы избежать инфицирования, все воспалительные процессы в органах мочеполовой системы необходимо устранять своевременно, до того как они станут хроническими.
Диабет любого типа
Сахарный диабет – единственное эндокринное расстройство, при котором происходит перестройка структуры слизистых оболочек организма – они истончаются. Изменение строения тканей снижает местный иммунитет, повышает риск их повреждения. Поэтому контакт кожи мужчины с вирусами на фоне диабета в 90% случаев приводит к инфицированию и появлению папиллом. Также наличие сахарного диабета становится препятствием для удаления папиллом лазерным лучом, жидким азотом или скальпелем.
Иммуносупрессорная терапия
При ревматоидном артрите, склеродермии и системной красной волчанке иммунная система начинает атаковать собственные ткани организма. В таких случаях оптимальным решением становится подавление защитных функций. Для этого пациентам назначается иммуносупрессивная терапия. Однако стоит отметить, что этот метод лечения имеет побочный эффект: уменьшая аутоиммунные реакции, он также увеличивает риск заражения различными инфекциями. Снижение иммунной защиты делает организм более уязвимым к атакам патогенных микроорганизмов, включая папилломавирус.
Алкоголизм, наркомания
Регулярная интоксикация организма – благоприятное условие для инфицирования бактериями, вирусами, грибками, простейшими и другими возбудителями. Причина – значительное снижение иммунитета. Поэтому лечение начинают с устранения зависимости – никотиновой, наркотической, алкогольной. Если речь идет о применении запрещенных сильнодействующих препаратов, требуется детоксикация организма, и уже после – лечение ВПЧ. Очищение крови с помощью капельного введения растворов «разгружает» печень, почки и сердце от токсинов, накопленных за время зависимости.
Воздействие стрессовых факторов
Проблемы в личной жизни или на рабочем месте, а также адаптация к новым условиям, например, при переезде, могут стать источником стресса, который негативно сказывается на иммунной системе. Хотя ослабление защитных функций организма не является непосредственной причиной появления папилломавируса, оно создает условия, способствующие его развитию. В результате психоэмоциональных стрессов нарушается гормональный баланс, и снижается выработка антител, необходимых для борьбы с вирусами, попадающими в кровь. В конечном итоге, при контакте с поверхностями, содержащими ВПЧ, вероятность заражения и возникновения инфекционного процесса значительно возрастает.
Переливание крови
Когда донор сдает кровь, основной фактор, на который ее проверяют – групповая и резус-принадлежность. Наличие такого возбудителя, как вирус папипилломы, может остаться незамеченным. Если ранее по разным показаниям мужчина проходил гемотрансфузию, и ему перелили кровь донора, страдающего ВПЧ, с вероятностью в 100% происходит инфицирование. Поэтому при обращении к врачу относительно лечения папилломавируса, нужно сообщить ему о перенесенных медицинских манипуляциях.
Провоцирующие факторы
Для активации вируса необходимо, чтобы иммунная система ослабила свои защитные функции. Это может произойти в следующих ситуациях:
- Наличие вредных привычек, таких как употребление наркотиков, курение и чрезмерное потребление алкоголя.
- Работа в условиях вредного производства, где организм подвергается постоянной интоксикации.
- Постоянные стрессы и состояние депрессии.
- Частые простудные заболевания.
- Долговременный прием медикаментов, включая иммуносупрессоры и гормональные препараты.
- Наличие воспалительных процессов, хронических заболеваний и инфекций, передающихся половым путем.
- Нарушения обмена веществ.
При появлении хотя бы одного из этих факторов иммунная система может дать сбой, что приведет к снижению ее способности противостоять вирусу.
Как происходит развитие болезни
После попадания микроорганизм проникает в кровяное русло и распространяется по организму. Сразу после внедрения в клетки-мишени он начинает активное встраивание своей нити ДНК в спираль клетки. ДНК вируса включает в клетке новую генетическую программу, рассчитанную на быстрое деление. Из-за неограниченных делений на коже появляются выросты, характерные для вируса папилломы человека.
Течение заболевания делится на несколько этапов:
- Латентный (скрытый) период. Любые симптомы на протяжении инкубационного периода отсутствуют, поэтому больной сам не знает о начале инфицирования. Несмотря на отсутствие клинических проявлений, мужчина способен заразить партнершу во время секса. Инкубационный период продолжается от пары месяцев до нескольких лет, пока иммунная система не получит стресс.
- Начало активной стадии. К этому моменту возбудитель наращивает свое присутствие в клетках организма настолько, что провоцирует появление первых симптомов.
- Стадия активного прогресса. Все проявления в этот период происходят очень выраженно и интенсивно нарастают.
После достижения клинического максимума заболевание развивается по одному из возможных направлений:
- полное самоизлечивание организма с окончательным исчезновением всех признаков инфекции;
- медленное течение или остановка развития выростов (инфекция не проходит, но и не прогрессирует);
- быстрый прогресс всех симптомов, возникновение вторичного инфицирования, увеличение площади очагов поражения;
- переход к злокачественному течению.
Типы выростов
Внешний вид образований, их размеры, формы и количество при наличии ВПЧ зависят от штамма вируса, поскольку все проявления инфекции определяются его генетической структурой.
Все такие образования можно отнести к эндофитным или экзофитным группам.
Эндофитные образования
Такие образования врастают вглубь эпителия или кожи, поэтому иногда бывают плохо заметными при осмотрах. Могут располагаться как под самой поверхностью покровов, так и проникать на достаточную глубину. Имеют ножку или корешок, которые со временем проявляют тенденцию к удлинению.
Эндофиты представлены внутриэпителиальными бородавками, поражающими более глубокие слои дермальной ткани. Такие бородавки чаще всего обнаруживаются в паху. Они имеют выпуклую верхушку, ровные края и цвет, не отличающийся от остальной кожи. После появления они не вызывают болезненных ощущений, зуда или других дискомфортных ощущений. Кроме паховой зоны, могут локализоваться на ступнях или коже ладоней.
Экзофитные образования
Явно выступают над общим уровнем кожного покрова и характеризуются наружным ростом.
Наружные выросты подразделяются на:
- Папулы. Эти образования слегка возвышаются над эпидермисом и формируют плоские структуры с неровной поверхностью. По цвету они могут быть как схожи с кожей, так и немного темнее окружающих тканей. Чаще всего располагаются на подошвах, лице и туловище.
- Плоские кондиломы. Обладают высокой скоростью роста. Их появление часто сопровождается выраженным зудом и жжением. При пальпации они ощущаются как довольно твердые выросты. На поздних стадиях плоские кондиломы могут значительно повреждать окружающие ткани.
- Остроконечные кондиломы. Напоминают столбики, которые поднимаются над слизистой оболочкой. Наиболее распространенные места их появления — головка полового члена и венечная борозда. Реже они встречаются на стволе пениса, в области ануса или прямой кишки. Кондиломы могут быть как одиночными, так и образовывать большие скопления. Иногда их наличие сопровождается резким неприятным запахом.
Помимо эндофитных и экзофитных форм, существует также смешанный тип — образования Бушке-Левенштейна. Они характеризуются быстрым ростом в двух направлениях — как вверх, так и вглубь. Эти образования всегда имеют значительные размеры и могут вызывать периодические рецидивы.
Все виды наростов могут быть как одиночными, так и групповыми. При этом наблюдается прямая связь между увеличением площади поражения и ухудшением состояния мужчины, а также ростом дискомфорта. Большие группы могут трескаться, кровоточить, присоединять вторичные инфекции и выделять жидкость.
Папилломавирус: типы и генотипы
На сегодняшний день папиломавирус является одной из наиболее распространенных инфекций, способных передаваться половым путем. Если науке известно всего 150 видов папилломавируса, из них только 34 могут быть генитальными и передаваться через секс.
По степени онкогенного риска (способности вызывать рак и предраковое состояние) вирусы подразделяются на безопасные и группы низкого или высокого риска.
Онкогенно безопасные типы папилломавируса:
- 1; <=”” li=””>
- 2; <=”” li=””>
- 3; <=”” li=””>
- 4; <=”” li=””>
- 5; <=”” li=””>
- 39; <=”” li=””>
- 45; <=”” li=””>
- 50; <=”” li=””>
- 51; <=”” li=””>
- 52; <=”” li=””>
- 56; <=”” li=””>
- 58; <=”” li=””>
- 59; <=”” li=””>
- 64; <=”” li=””>
- 68.
Типы папилломавируса человека с высоким риском развития онкозаболеваний (онкогенные):
- 16; <=”” li=””>
- 18; <=”” li=””>
- 31; <=”” li=””>
- 33; <=”” li=””>
- 35; <=”” li=””>
- 44; <=”” li=””>
- 53; <=”” li=””>
- 54; <=”” li=””>
- 61; <=”” li=””>
- 72; <=”” li=””>
- 73; <=”” li=””>
- 81.
Типы папилломавируса с низким риском развития онкозаболеваний:
- 6; <=”” li=””>
- 11; <=”” li=””>
- 40; <=”” li=””>
- 42; <=”” li=””>
- 43.
Папилломавирус человека 1-5 типов считается онкогеннобезопасным, однако эти 5 типов, а также 7, 10, 12 и 14, 15, 17, с 19 по 24, 26-27, 29 и 57 типы вызывают появление бородавочных новообразований на тканях тела. Группа типов низкого риска обычно провоцирует рост кондилом, изредка встречается у больных раком. Группа высокого риска обычно вызывает карциному.
Половые органы мужчины обычно поражают 6, 11 и 13 генотип, 16 тип, 18, 31, 33 и 35, вызывая появление на пенисе папиллом и кондилом остроконечных. Если мужчина болеет вирусом папилломы человека 16, 18, 31, 33, 56 и 66, 70 генотипа, он находится в группе повышенного риска развития онкологических болезней половых органов. Будучи носителем одного из перечисленных типов вируса, мужчина должен регулярно проверяться у врача и делать анализы на онкомаркеры, чтобы вовремя остановить развитие опасной болезни.
Каждый из этих типов папиллома вируса мужчина может получить от своего сексуального партнера или бытовым путем, так же он может и заразить окружающих.
Какие виды папилломавируса встречаются у мужчин?
Как только иммунная система мужчины ослабевает, начинается проявление вируса папилломы. Существует около ста различных типов этого вируса, которые отличаются друг от друга как внешним видом, так и местами локализации на теле.
Наиболее распространенные виды папиллом у мужчин:
- Простая бородавка. Эти образования могут появляться на разных участках кожи, таких как руки, пальцы, колени и плечи. Они представляют собой небольшие наросты размером до 1,5 мм, имеют телесный цвет и выступают над кожей в виде ороговевшей, пористой ткани.
- Бородавка на подошве. Это довольно распространённая проблема, связанная с образованием наростов на внутренней стороне стопы. Такие папилломы могут вызывать дискомфорт при ходьбе, беге и других нагрузках на стопу. Они имеют желтовато-коричневый цвет и плотную структуру.
- Плоская папиллома. Этот тип папилломы может появляться на лице и руках мужчин. Она представляет собой маленькое, почти незаметное образование размером в несколько миллиметров и имеет цвет, схожий с цветом кожи.
- Нитевидная папиллома. В группу риска попадают мужчины старше 45 лет. Этот вид вируса папилломы может возникать на определенных участках лица, таких как веки и уголки рта, а также в паховой и подмышечной областях, где кожа постоянно трется о одежду.
- Остроконечные кондиломы. Этот тип вируса передается половым путем и появляется на половых органах мужчин. Остроконечные образования представляют собой серьезную опасность. Во-первых, они могут вызывать болезненные ощущения у инфицированного мужчины. Во-вторых, они негативно влияют на психоэмоциональное состояние. В-третьих, данный тип вируса папилломы может трансформироваться в злокачественное образование. Риск развития онкологии в этом случае значительно увеличивается, если не начать своевременное лечение.
Опасность ВПЧ для мужчин
В качестве профилактики ВПЧ, стоит ограничить количество половых партнеров и использовать барьерные методы контрацепции.
Представитель сильного пола, зараженный ВПЧ, может быть просто его носителем и даже не иметь об этом не малейшего представления. Но при этом зараженный мужчина являет собой угрозу для сексуальных партнеров и прочих домочадцев, которые могут воспользоваться предметами личной гигиены зараженного. Передается вирус быстро и является намного опаснее для женского организма, чем для мужского. ВПЧ – это довольно-таки коварный вирус, потому что его на начальных этапах развития трудно заметить.
Опасность заболевания для представителей мужского пола заключается в том, что инфекция, после длительного нахождения в организме начинает разрушать клеток и появлению раковых опухолей в районе мужских гениталий. Степень опасности инфекции для мужчин зависит от штамма вируса.
Большинство разновидностей вируса не причиняют организму серьезный вред, но некоторые типы инфекции представляют собой большую опасность для мужского организма. Поэтому, лечение ВПЧ у мужчин – это обязательный момент.
Если инфекция поражает уретру изнутри, то внутри мочеиспускательного канала начинают образовываться кондиломы, что образует закупорку канала и оказывает плохое влияние на работу мочеполовых органов. Также папиллома у мужчин может появиться на гениталиях, возле сфинктера или внутри прямой кишки. Такие наросты обладают высокой вероятностью преобразования из доброкачественной опухоли в онкологию.
Какой врач лечит папилломы у мужчин?
Вирус папилломы человека представляет собой многогранное заболевание, затрагивающее различные области медицины. Первоначально пациентам следует обратиться к терапевту и инфекционисту.
После анализа клинической истории болезни, врач направляет пациента на консультации к следующим специалистам:
- Уролог-андролог (если наблюдаются наросты в области паха или на половом члене);
- Проктолог (в случае появления новообразований в ректальной области);
- Врач-онколог (при наличии подозрений на злокачественные образования);
- Венеролог-дерматолог.
Решение о необходимости удаления новообразований принимается совместно с несколькими специалистами. Перед этим проводится тщательная диагностика для исключения онкологических опухолей и других заболеваний с аналогичными симптомами.
Как сдать анализ на ВПЧ мужчине — диагностические мероприятия
Для окончательного диагноза важно сдать некоторые анализы, пройти обследование.
Исследование мужчин на вирус папилломы человека включает следующие манипуляции:
- Анализ крови на ВИЧ и инфекции, передающиеся половым путём;
- Полимеразная цепная реакция для определения вируса по его ДНК (изучаемый материал — кровь, семенная жидкость, секрет простаты, уретральная слизь);
- Анализ мочи для исключения острых мочеполовых инфекций;
- Уретроскопия (эндоскопический метод исследования просвета мочеиспускательного канала);
- Мазок из анального канала (исследование требуется при определении ВПЧ у гомосексуалистов, любителей нетрадиционного секса);
- Соскоб из уретры.
Эффективным анализом в диагностике является биопсия. Гистологическое исследование удалённых новообразований помогает исключить или подтвердить наличие раковых клеток и предупредить развитие онкологического заболевания.
Как и чем лечить вирус папилломы человека у мужчин?
Лечение вируса папилломы человека может быть как консервативным, так и хирургическим. В первом случае применяется комплекс системных и местных медикаментов, которые помогают снизить активность вируса и облегчить неприятные симптомы. Хирургическое вмешательство, в свою очередь, устраняет только видимые проявления заболевания, но не гарантирует отсутствие рецидивов. При ослаблении иммунной системы новообразования могут появляться в других участках, а инфекция продолжает развиваться.
Консервативное лечение считается наиболее перспективным подходом.
Специалисты назначают следующие группы препаратов:
- Противовирусные средства, которые подавляют активность вирусных штаммов (например, Ацикловир, Валацикловир);
- Иммуномодуляторы, способствующие укреплению иммунной системы (такие как Виферон, Генферон, Изопринозин, Аллокин-Альфа);
- Препараты, стимулирующие выработку собственного интерферона (например, Индинол, Циклоферон, Амиксин);
- Цитостатические средства, применяемые как системно, так и местно, для остановки патологического деления клеток эпидермиса (Кондилин, Подофиллин).
Тактика лечения ВПЧ у мужчин строится на основе полученных диагностических данных. Терапия подбирается индивидуально, в зависимости от конкретного вирусного штамма. Местное лечение всегда носит симптоматический характер и направлено на устранение зуда, жжения и покраснения кожи.
Хирургическое вмешательство может осуществляться с помощью:
- электрокоагуляции (прижигание электрическим током),
- криодеструкции (лечение с использованием жидкого азота),
- радиоволновой терапии (удаление с помощью радионожа),
- лазерного иссечения (прижигание с использованием лазера).
Также существует традиционное удаление с помощью скальпеля.
Важно! По результатам многочисленных исследований, рак простаты, кишечника и органов малого таза может быть следствием ранее перенесенной папилломавирусной инфекции.
Высокие онкогенные риски, выявленные в ходе гистологического исследования, требуют особого терапевтического подхода под контролем врача-онколога.
Эффективные препараты и схема приёма
Часто назначаемыми лекарственными средствами являются следующие:
- Кислота салициловая спиртовая (2%). Недорогое и эффективное средство для обработки бородавок, папиллом и кондилом. Длительность курса — 2-3 месяца.
- Уколы Блеомицин. Инъекцию ставят внутрь новообразования с инфекционным очагом. Курс лечения 1 месяц с уколом 1 раз в неделю. Инъекции препарата болезненные, могут отмечаться изменения цветности кожных покровов в области укола. Среди побочных явлений выделяют отслоение ногтевых пластин, выпадение волос. Среди противопоказаний беременность и лактация.
- Мазь Имиквимод. Препарат местного назначения для обработки патологических наростов на коже в домашних условиях. Достаточно смазывать участки 3-4 раза в неделю. Распространёнными побочными явлениями считаются аллергические реакции, зуд и эрозивное поражение кожи. Такие реакции встречаются у людей с белой или прозрачной кожей. Недопустимо использовать при беременности в любой период гестации.
- Спрей Эпиген с глицирризиновой кислотой. Препарат подходит для лечения бородавок. Курс лечения 5 суток с распрыскиванием каждые 4 часа. При недостаточном эффекте следует обрабатывать кожу 10-14 суток по рекомендации лечащего врача.
- Раствор Ферезол. Средство для обработки кожных покровов в течение 5 суток по 3-4 раза в сутки. Обработка проводится локально, в пределах здоровых тканей. Препарат обладает выраженным противовоспалительным действием, что особенно важно при инфицировании новообразований. Обычно после курса в неделю папиллома или бородавка отпадает. При отсутствии терапевтического эффекта можно увеличить курс лечения по рекомендации врача. Препарат не применяют в педиатрической практике, при беременности и при бородавках у пациентов старше 60 лет.
- Подофиллотоксин. Средство для обработки кожных покровов при папилломах и бородавках на фоне ВПЧ. Курс лечения 5 дней, после чего следует сделать перерыв в 2-3 дня. Общий курс терапии не должен превышать 30 дней. Побочными реакциями со стороны кожных покровов являются отёчность, покраснение, аллергические реакции.
- Раствор Солкодерм. Препарат для однократной обработки поражённой поверхности кожи. Суточная доза 0,2 мл препарата. Общая площадь обработанной поверхности кожи не должна превышать более 5 см. Средство не применяют при беременности, язвенных и травматических поражениях кожи в области нароста.
Все препараты назначаются только после диагностики и выявления вирусного штамма. Самостоятельная терапия в лучшем случае не принесет результатов, в худшем – спровоцирует раковые трансформации клеток.
Таблетки, капсулы и инъекции
Противовирусная терапия играет важную роль в лечении ВПЧ с высоким онкогенным риском, особенно в случаях, связанных с 16 и 18 типами папилломавируса. Она помогает предотвратить образование новых образований и снизить вирусную нагрузку в организме. Все медикаменты подбираются индивидуально, так как они могут иметь множество противопоказаний и вызывать побочные эффекты. Применяемые препараты представлены в таблице:
| Название | Описание |
| Изопринозин | Противовирусные таблетки с иммуномодулирующим эффектом. Рекомендуемая доза – 2 таблетки трижды в день. Курс лечения устанавливается индивидуально, но должен составлять не менее 2 недель. |
| Гроприносин | Более доступный аналог Изопринозина, обладающий иммуномодулирующими свойствами. Рекомендуется принимать по 2 таблетки 3-4 раза в день в течение месяца. |
| Галавит | Российский препарат с противовирусным действием. Активное вещество – аминодигидрофталазиндион натрия. Таблетки противопоказаны при индивидуальной непереносимости. Рекомендуемая доза – 4 капсулы в сутки, при ВПЧ 16 типа и высокой вирусной нагрузке врач может увеличить дозировку. |
| Ликопид | Эффективность препарата обусловлена наличием активного фрагмента бактериальной клеточной стенки, который стимулирует иммунную систему к выработке антител. Ликопид обладает противовоспалительными и регенеративными свойствами. Рекомендуется принимать по 10 мг в течение 10 дней. При поражении половых органов необходимо пройти 3 курса лечения с интервалом в 2 недели. |
| Циклоферон | Доступный препарат на основе интерферона. Он активизирует иммунную систему и помогает остановить вирусную активность. Дозировка и продолжительность лечения определяются индивидуально. |
| Алпизарин | Препарат, эффективный против ВПЧ, герпеса и ветряной оспы. Рекомендуется принимать по 2 таблетки трижды в день. Курс лечения составляет 3 недели. |
| Римантадин | Один из недорогих антивирусных средств, применяемых для лечения ВПЧ. Обладает иммуномодулирующими свойствами и снижает риск инфицирования здоровых участков кожи и слизистых. Рекомендуемая доза – 2 таблетки трижды в день. |
При выявлении вируса ВПЧ с высоким онкогенным риском в схему лечения включаются иммуномодулирующие препараты. Наиболее эффективными являются инъекционные средства, однако при отсутствии возможности их введения можно использовать таблетки или свечи. Назначение иммуномодуляторов должно основываться на результатах иммунограммы. В терапию могут входить ректальные свечи Виферон и Генферон, курс лечения которыми составляет 10 дней.
К числу эффективных иммуномодуляторов в таблетированной форме относятся:
- Вобэнзим;
- Ликопид;
- Деринат.
Иммуномодуляторы не всегда включаются в схему лечения ВПЧ. Их применение оправдано при наличии вируса с высоким онкогенным риском, множественных папилломах, рецидивирующих после удаления кондилом, папилломатозе гортани и обширном поражении аногенитальной области. Эти препараты противопоказаны людям с аутоиммунными заболеваниями и диабетом 1 типа.
Витамины и иммуностимуляторы
Лечение ВПЧ при образовании наростов на головке, во рту и вокруг ануса проводят комплексно. Бородавки и папилломы не всегда нужно удалять, однако подавить вирус следует обязательно. К витаминным комплексам, призванным восполнить недостаток микроэлементов, относят Дуовит, Компливит, Аевит.
Препараты с интерфероном помогают снизить вирусную нагрузку на организм зараженного человека. Лекарства вводят внутривенно и внутримышено. Их можно применять в виде свечей и таблеток. Самые известные интерфероны – Интрон А, Генферон, Веллеферон и Виферон.
Иммуностимуляторы повышают защитные свойства организма. Синтетические лекарственные средства применяются как при бессимптомном развитии ВПЧ, так и при развитии ярко выраженных симптомов. Иммуностимуляторы часто используют наряду с противовирусными препаратами и хирургическими методами.
К распространенным средствам относят:
- Иммуномакс;
- Кемантан;
- Гепон.
Они предотвращают размножение вируса и ускоряют заживление пораженных участков.
Деструктивные методы
Эти методы быстро облегчают состояние пациента при ВПЧ, особенно в случаях значительных очагов поражения или разрастаний в области уретры и анального отверстия, поскольку по достижении определенных размеров бородавки и кондиломы теряют способность к заживлению.
Удаление новообразований возможно с использованием следующих методик:
- Хирургическое иссечение. Этот метод требует местного или полного наркоза. После удаления образований рана зашивается хирургическим швом. Ранее хирургическое иссечение считалось основным способом решения данной проблемы, но из-за частых постоперационных осложнений и кровотечений в настоящее время его применяют довольно редко.
- Криодеструкция. В этом методе используются жидкий азот, который вымораживает клетки новообразований, разрушая их белки. В результате бородавки усыхают и отпадают. Преимуществом является отсутствие необходимости в наркозе и чистота кожи без образования рубцов после заживления.
- Лазерная терапия. Эта методика напоминает косметическую процедуру. Анестезия чаще всего достигается с помощью специального крема. Лазер направляется на пораженную область, и его луч разрушает ножку или корень новообразования. Недостатками являются болезненность, высокая стоимость и вероятность появления шрамов после процедуры.
- Электрокоагуляция. Этот метод доступен по цене, но может быть болезненным. Для уменьшения дискомфорта проводится местное обезболивание, однако чувствительность все равно сохраняется. Под воздействием тока в нежелательных клетках создается высокая температура, что приводит к прижиганию. Через несколько дней образуются корочки, которые отпадают, оставляя рубцы.
- Радиохирургия. Этот метод использует электрод радиоволнового типа для удаления крупных и средних наростов с предварительной обработкой кожи антисептиками. Эта современная и бесконтактная технология практически исключает осложнения. Заживление ранок происходит в рекордные сроки — всего за сутки. Единственным недостатком является высокая стоимость.
- Химическая коагуляция. Этот метод имеет ограничения и подходит только для средних по размеру образований. Отмирание клеток происходит при контакте с мощным химическим реагентом на основе высококонцентрированных щелочей или кислот. В результате воздействия возникает химический ожог, что может привести к образованию шрамов и рубцов.
Лечение не должно ограничиваться только деструктивными методами, так как после их самостоятельного применения в 30% случаев может произойти рецидив. Поэтому радикальные способы обязательно должны дополняться медикаментозной терапией.
Лечение народными средствами в домашних условиях
К сожалению, народные методы терапии не позволяют подавить патогенную активность вирусных штаммов. Клиницисты рекомендуют воспользоваться альтернативными методами при невозможности проведения традиционной медикаментозной терапии.
К основным рецептам для лечения внешних проявлений заболевания относят:
- Сок чистотела травы. Сок добывают из свежей травы при помощи мясорубки или блендера. Жмых процеживают, а жидкость помещают в стеклянный флакон. Срок хранения приготовленного состава — 5 суток в холодильнике. Прижигать следует локально, в пределах здоровой кожи. Длительность терапии — 14 дней с перерывом в 3-4 дня. Длительность лечения определяется терапевтическим результатом.
- Уксусная эссенция с чесночным соком. 10 г уксуса гасят 50 мл чистой воды и добавляют сок из тёртого чеснока. В составе смачивают небольшой бинтик и закрепляют его лейкопластырем на сутки. Обычно через несколько суток новообразования отпадают.
В народной медицине также используют прижигание керосином и йодом, проводят обработку льняным и касторовым маслами с предварительной обработкой хозяйственным мылом. Все эти методы требуют длительной курсовой терапии до нескольких месяцев.
Прогноз при вирусе папилломы человека обычно благоприятный, однако онкогенные риски возрастают в разы. Основной акцент на развитие симптоматического комплекса у мужчин клиницисты ставят на сниженный иммунитет и беспорядочные половые связи. Своевременная терапия и организация здорового жизни значительно снижает риски инфицирования и активности патогенных штаммов.
Вакцинация
Существует две вакцины против вируса папилломы человека: Церварикс и Гардасил. Оба препарата способствуют формированию иммунной защиты от ВПЧ и хорошо переносятся как взрослыми, так и детьми. У большинства пациентов не наблюдаются побочные эффекты.
Наиболее эффективно проводить вакцинацию девушек и юношей до начала половой жизни, когда риск инфицирования еще минимален.
Вакцина Гардасил защищает от типов 6, 11, 16 и 18 ВПЧ, в то время как Церварикс – от 16 и 18 типов. Если уже произошло инфицирование этими типами вируса, вакцинация не принесет пользы.
Стандартный график вакцинации включает три прививки. Вторая делается через 1-2 месяца после первой, а третья – через полгода. Вакцины вводятся внутримышечно в область предплечья.
Процедура вакцинации противопоказана во время беременности, при наличии аллергии на любой из компонентов препарата, а также при обострении хронических заболеваний и острых воспалительных процессах в организме.
Лечение ВПЧ – это длительный и затратный процесс, который должен проходить под наблюдением квалифицированного специалиста. Не рекомендуется заниматься самолечением и бесконтрольно принимать медикаменты. Только врач, основываясь на общей клинической картине и результатах анализов, сможет назначить правильную терапию.
Почему часто мужчина только носитель вируса
Женский и мужской организм одинаково подвержен влиянию ВПЧ. Мужчины чаще являются переносчиками заболевания, нежели сталкиваются с внешними симптомами. Подобное сложно объяснить, сильный пол склонен к возникновению вирусных образований в зоне паха.
Женщины подвержены изменениям работы организма. Снижение естественной защиты у женщин наблюдается перед каждой менструацией, на этапе гормонального дисбаланса, во время беременности. По данной причине женщины часто сталкиваются с признаками кандидоза. Неважно для развития рака. Главным фактором является повреждение эпителия шейки матки в зоне эрозии (незаживающей раны) внедряется ВПЧ и чувствует себя вполне вольготно. Эрозия преобразуется в дисплазию, ВПЧ сопровождает процесс малигнизации шейки матки.
Защитная функция организма мужчины стабильна. Спровоцировать угнетение иммунитета могут только острые заболевания, длительное медикаментозное лечение или серьезное воздействие внешних факторов.
У мужчины меньшая вероятность заразится папилломавирусом, так как строение полового органа обеспечивает целостность кожного покрова. Пенис меньше страдает от трения во время контакта, чем женское влагалище. Исключением являются пассивные гомосексуалисты, риск заражения у которых выше, чем у женщин.
Осложнения болезни
Наиболее серьезным и опасным последствием вируса папилломы является рак. ВПЧ может способствовать развитию онкологических заболеваний, таких как рак простаты, полового члена и прямой кишки, причем последнее осложнение чаще встречается у мужчин, ведущих гомосексуальный образ жизни.
Кроме того, вирус способен вызывать образование новообразований в различных участках тела, что может затруднять нормальные физиологические процессы. Это может происходить в уретре, носоглотке, трахее, бронхах и других каналах организма.
К сожалению, такие изменения сопровождаются болезненными ощущениями и нарушением нормальной работы организма.
Последствия
Кроме того, что мужчина, инфицированный папилломавирусом, представляет угрозу для своего полового партнера, он также подвергается риску развития осложнений, опасных для собственного здоровья.
- Папилломы в уретре
- Если папилломы образуются в мочеиспускательном канале, то при отсутствии лечения они разрастаются, частично или полностью закупоривая канал. Это приводит к нарушениям мочевыделения, воспалительным процессам и развитию различных патологий мочеполовой системы.
- Образование папиллом на головке члена или в области анального отверстия, может указывать на заражение мужчины онкогенным штаммом вируса. У гетеросексуальных мужчин в этом случае ВПЧ приводит к раку простаты, у гомосексуалистов значительно возрастает риск рака прямой кишки. Оральный секс нередко является причиной образования папиллом в горле.
- Оставляя без внимания и лечения Впч, мужчины рискуют столкнуться с таким заболеванием, как плоскоклетчатый рак члена.
Профилактические меры
Наиболее действенной мерой для предотвращения заражения вирусом папилломы человека (ВПЧ) является вакцинация. Вакцинальный курс состоит из трех инъекций, которые проводятся с интервалом в полгода. В России доступны две вакцины – Гардасил и Церварикс, которые различаются по своему составу: Церварикс защищает от белков папилломавирусов 16 и 18 типов, в то время как Гардасил обеспечивает защиту от ВПЧ 6, 11, 16 и 18 типов. Однако, согласно рекомендациям Всемирной организации здравоохранения, мужчинам следует использовать только вакцину Гардасил, так как Церварикс не проходил клинические испытания на мужской половине населения.
Вакцину необходимо вводить исключительно внутримышечно, в бедро или плечо. Введение в ягодичные мышцы может привести к высокому риску повреждения седалищного нерва или попадания в жировую ткань. В редких случаях вакцинация может вызывать защитные реакции организма, такие как повышение температуры, головные боли и общую слабость.
Существуют и противопоказания: вакцинацию не следует проводить людям с аллергией или тем, кто страдает от обострения других заболеваний. Также в показаниях к применению указано, что вакцины рекомендуется вводить только лицам младше 26 лет, так как нет достаточных клинических данных о переносимости и иммунных реакциях у более старших возрастных групп.
Тем не менее, хотя вирус папилломы человека представляет собой серьезную угрозу, его можно вылечить. При правильном лечении возможно подавить развитие вируса и полностью устранить все его симптомы, что исключает риск рецидива. Однако выбор курса лечения должен осуществляться только квалифицированным дерматологом после полного обследования пациента. Следите за своим здоровьем, и при любых сомнениях обращайтесь к врачу. Будьте здоровы!
Психологические аспекты и влияние ВПЧ на качество жизни мужчин
Вирус папилломы человека (ВПЧ) может оказывать значительное влияние на психологическое состояние мужчин, что в свою очередь сказывается на их качестве жизни. Поскольку ВПЧ часто ассоциируется с различными заболеваниями, включая рак половых органов, многие мужчины испытывают страх и тревогу по поводу своего здоровья. Это может привести к снижению самооценки и повышенной тревожности.
Одним из основных факторов, влияющих на психологическое состояние мужчин, является стигматизация, связанная с ВПЧ. Мужчины могут испытывать чувство стыда или вины из-за своего диагноза, особенно если они считают, что могли передать вирус своим партнёршам. Это может привести к избеганию открытых разговоров о здоровье и сексуальности, что, в свою очередь, усугубляет чувство изоляции и одиночества.
Кроме того, наличие ВПЧ может повлиять на интимные отношения. Мужчины могут бояться, что их партнёрши будут отвергать их или испытывать страх перед заражением. Это может привести к снижению сексуальной активности и ухудшению отношений, что негативно сказывается на эмоциональном состоянии. Партнёрши также могут испытывать беспокойство, что может вызвать дополнительные напряжения в отношениях.
Важно отметить, что мужчины, столкнувшиеся с ВПЧ, могут испытывать различные эмоциональные реакции, включая гнев, депрессию и беспокойство. Эти чувства могут быть вызваны не только самим диагнозом, но и последствиями, такими как необходимость медицинского вмешательства или изменения в образе жизни. Понимание этих эмоций и их влияние на качество жизни является важным шагом к улучшению психоэмоционального состояния.
Для поддержки мужчин, столкнувшихся с ВПЧ, важно создать безопасное пространство для обсуждения их переживаний. Психологическая помощь, включая терапию и группы поддержки, может оказать значительное влияние на улучшение качества жизни. Обсуждение своих чувств и получение информации о заболевании может помочь снизить уровень тревожности и повысить уверенность в себе.
В заключение, влияние ВПЧ на психологическое состояние мужчин является важным аспектом, который не следует игнорировать. Понимание и поддержка со стороны близких, а также доступ к профессиональной помощи могут значительно улучшить качество жизни мужчин, сталкивающихся с этим вирусом.
Вопрос-ответ
Каковы симптомы ВПЧ?
Вирус папилломы человека (ВПЧ) может проявляться различными симптомами, в зависимости от типа вируса. Наиболее распространенные симптомы включают появление бородавок или кондилом на коже и слизистых оболочках, особенно в области половых органов, ануса и рта. В большинстве случаев инфекция протекает бессимптомно, и многие люди не осознают, что являются носителями вируса. В некоторых случаях ВПЧ может привести к предраковым изменениям шейки матки или другим онкологическим заболеваниям.
Как убрать ВПЧ у мужчин?
Так как на сегодня методик полного уничтожения вируса в организме человека не существует, то основные методы направлены на удавление образований и подавление активности ВПЧ. Для удаления папиллом и других образований используют: химиодеструкцию, криотерапию.
Как очистить организм от вируса папилломы?
Резюме. Специфического лечения пациента, зараженного вирусом папилломы человека, не существует. Единственный действенный метод предотвратить заражение — вакцинация.
Советы
СОВЕТ №1
Регулярно проходите медицинские осмотры и обследования, особенно если у вас есть риск заражения ВПЧ. Это поможет выявить вирус на ранней стадии и предотвратить возможные осложнения.
СОВЕТ №2
Обратите внимание на симптомы, такие как бородавки или изменения на коже. Если вы заметили что-то необычное, не откладывайте визит к врачу для диагностики и возможного лечения.
СОВЕТ №3
Рассмотрите возможность вакцинации против ВПЧ. Вакцина может значительно снизить риск заражения и развития связанных с вирусом заболеваний, включая рак.
СОВЕТ №4
Поддерживайте здоровый образ жизни: правильное питание, регулярные физические нагрузки и отказ от вредных привычек помогут укрепить иммунную систему и снизить риск активизации вируса.